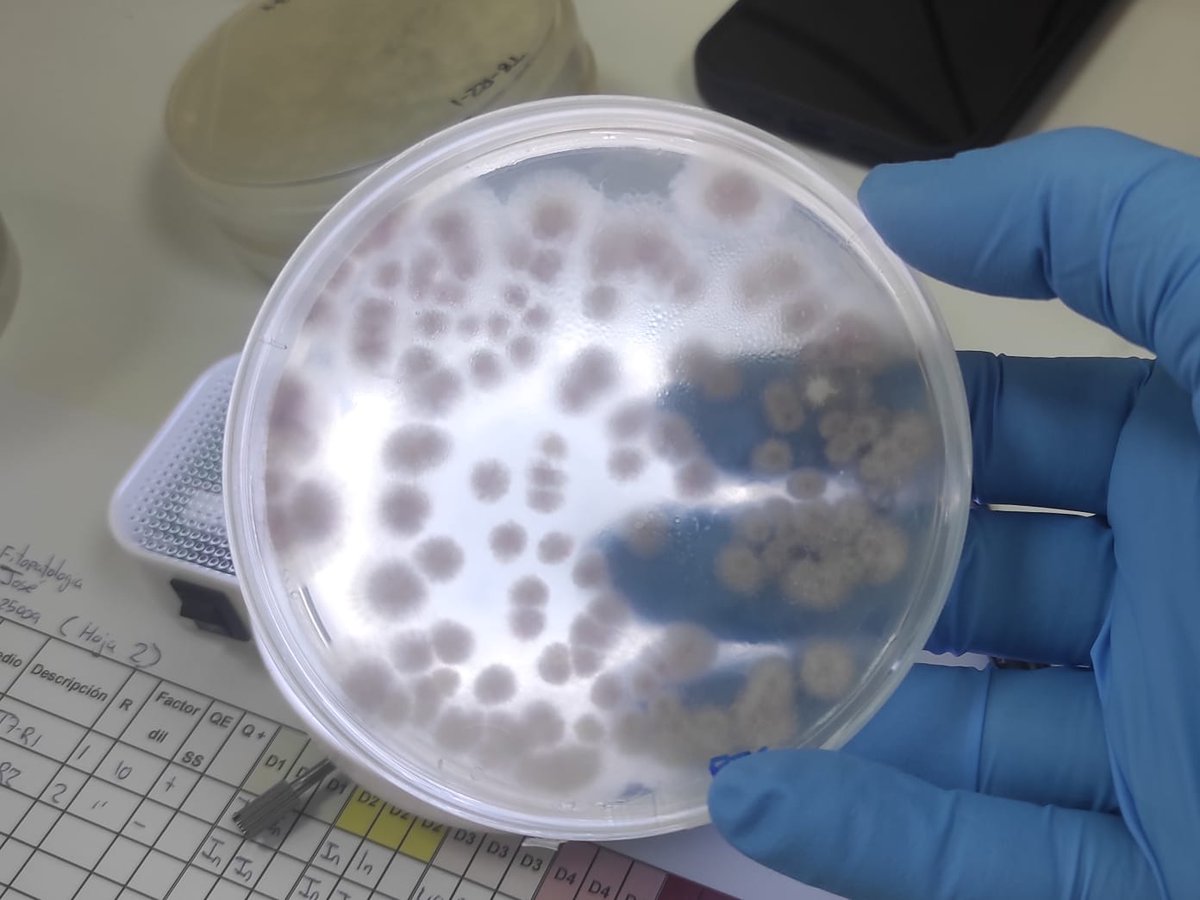
🧪🌱 Esta semana en #IDEAGRO analizamos la eficacia de nuevos productos con metabolitos y #microorganismos para controlar el #hongo #fitopatógeno #Fusarium.

Nuestros proyectos I+D 👉🏼 ideagro.es/investigacion-…

IDEAGRO
@ideagro
Investigación & Desarrollo Agroalimentario. Te ayudamos a hacer mejor lo que ya sabes hacer. Innovate outsourcing your R&D. #somosIDEAGRO & #IDEAGROteam
ID: 443774751
http://ideagro.es 22-12-2011 14:41:02
26,26K Tweet
17,17K Followers
2,2K Following

🌱🔬 #SOS - Safeguard Our Soils refleja nuestro compromiso con Alltech Spain de brindar información sobre #suelos, #microbiomas, y fomentar la colaboración e #innovación para crear una #agricultura más resiliente para las generaciones futuras. ¡Únete!➡️ ideagro.es/nace-la-inicia…






🐛♻️ No te pierdas el nuevo taller demostrativo sobre el funcionamiento de una granja de insectos del golivlab-in. 📅 10/04 📍Milagro (Navarra) #ISONATUR 🕔 17:00h – 19:30h 📝 ¡Inscríbete! 👉 forms.office.com/e/fRVcZKspLK Más sobre #GOLIVLABIN ➡️ golivlab-in.es




🆕🗣️ #IDEAGRO colabora con Agromunity en su nueva edición de #Microbioma Academy 2025 de la mano de Pedro Palazón, para hablar sobre Integración de indicadores biológicos en la #salud de los #suelos. Más información 👉🏼 entradas.agromunity.com/microbioma-aca…